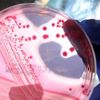
'Gen tedavisi' SMA hastaları için umut olacak

MORE IN SAĞLIK»

Manken Didem Soydan tacizcisini ifşa etti
15 Aralık 2017 13:48
'Obezite oranı 9,9'a yükseldi'
15 Aralık 2017 13:01
'Ses kısıklığı deyip geçmeyin'
15 Aralık 2017 13:01
Karlov suikastinde sıcak gelişme: Rus heyet Ankara'ya geliyor
15 Aralık 2017 18:47
CHP'li Gülay Yedekçi 2018 bütçesini Meclis kürsüsünde yırttı
15 Aralık 2017 18:47
Gürsel tekin'den Şişli'de "rayiç bedeli" tepkisi
15 Aralık 2017 18:47
118 yıllık tarihi saat kulesi restore ediliyor
15 Aralık 2017 15:55
Başkale Kaymakamlığı kadınları KETEM'e götürdü
15 Aralık 2017 13:51
Amerika'dan patent aldı
15 Aralık 2017 13:51
Ülkemizde her yıl 100 bini aşkın tüp bebek tedavisi yapılıyor
15 Aralık 2017 11:54
1,5 yaşındaki Muhammed ilik nakli ameliyatı için yardım bekliyor
15 Aralık 2017 11:54
Sağlıklı beslenme çocukları mutlu ediyor
15 Aralık 2017 11:54 resimsizD Vitamini hangi besinlerde bulunur?
15 Aralık 2017 11:53 resimsizEvde rutubetten kurtulmanın yolları
15 Aralık 2017 11:53 resimsizKış depresyonu, nedenleri ve tedavisi
15 Aralık 2017 11:53
Glutensiz diyet sektörü risk yaratıyor
15 Aralık 2017 11:50
Kalacak yeri olmayan kanser hastalarına yaşam merkezi
15 Aralık 2017 11:50HOTTEST NEWS IN SAĞLIK»
WHAT'S NEW IN SAĞLIK»
- Pfizer'ın koronavirüs hapı için lisans anlaş…
- Belçika'da aşı yaptırmayan sağlık personelin…
- Kepez DokumaPark'ta botanik bahçe açıldı
- Kayapınar Belediyesi'ne ‘TS EN ISO 9001 Kali…
- Manisa'da prestij cadde düzenlemeleri sürüyor
- Serik'te trafik kazası : 3 yaralı
- Karantinayı ihlal eden 2 kişi trafik uygulam…
- Kıbrıs Gazisi Yılmaz son yolculuğuna uğurlan…
- Ormanda üzerine ağaç devrilen Hakan öldü
- Burcu Esmersoy'un akşam yemeği şıklığı
- Pfizer, Kovid-19'a karşı ağızdan alınan ilaç…
- Covid-19'a yakalanan hamilelerde erken doğum…
- AB Adalet Divanı'ndan yargı bağımsızlığı kon…
- Doğumu kolaylaştıran yeni teknik literatüre …
- Sivas'ta doğumu kolaylaştıran teknik: Bilim …
- Türkiye'nin koronavirüs aşılama kampanyası k…
- Corona aşısından sonra sıra kanserde
- Koronavirüs erken doğum riskini arttırıyor
- "Fazla dezenfektan cilt kuruluğuna neden olu…
- Bilim Kurulu üyesinden 3. doz açıklaması!